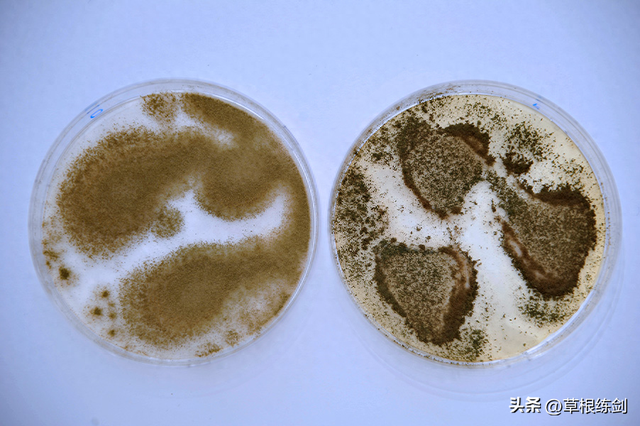
它曾经是剧毒霉菌，如今是酱料之王
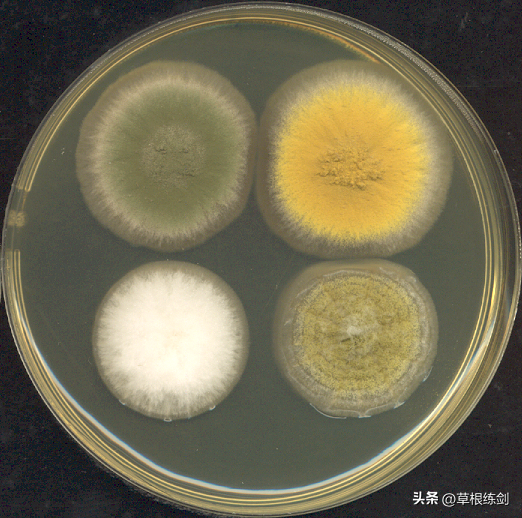
它曾经是剧毒霉菌，如今是酱料之王

米曲菌(它曾经是剧毒霉菌,如今是酱料之王)
2025-02-20
浏览量:次
资讯来自网络;中科院物理所 北京
以下文章来源于博物 ,作者博物
博物.博物,自然知道!
黄曲霉会产生黄曲霉素,这种致癌物已经“恶名昭著”了,然而它被驯化后却成了烹饪界的巨星——米曲霉,不仅能够发酵大米或大豆产生酱油和甜面酱,还能参与酿酒。
从黄曲霉到米曲霉,究竟发生了怎样的变化?几千年前甚至没有微生物概念的人类,又是怎样从有毒有害的霉菌中,选育出不产生毒素、专注于食品发酵的菌种的呢?关于微生物的驯化过程,我们依然知之甚少。
烹饪界的明星
在大约9000年前,玉米和猪刚开始被人类所驯化的时候,有人在“驯服”真菌。
其中一种真菌,米曲霉(Aspergillus oryzae),后来成为了烹饪界的巨星。它们不仅在生产酱油和甜面酱时出力,在东亚其他的传统食物中,也有它们的影子,比如日本的味噌和清酒——在日本,它们被称为“米麴菌”,有日本“国菌”之称。在酿酒时,它们是分解淀粉的高效糖化菌种,能促进其他菌完成发酵过程。
但米曲霉也不是完全无害的,它会引起工农业产品的霉变,每年对花生和玉米等作物造成数百万美元的损失。它的野生种黄曲霉(Aspergillus flavus)更是会产生一类致癌物黄曲霉素,对肝脏有很强的毒害作用,日常烹饪的温度下,这种强效致癌物质不会失活。
米曲霉(左)被认为是由黄曲霉(右)驯化而来,黄曲霉会产生剧毒致癌物黄曲霉素,尽管图片上的两个菌落差异明显,但它们在不同环境下的形态非常多变,在自然条件下并不好区分。
从毒株到“干饭株”
我们目前对驯化的几乎所有概念都来自于动物和植物,我们用肉眼就可以分辨狗和狼,玉米和大刍草之间的区别,但微生物被驯化主要是代谢产物的变化,我们无法用肉眼感受。
米曲霉属于真菌家族的散囊菌目,其中的许多成员被称为青霉或者绿霉。曲霉科的曲霉属是其中一个庞大的家族,分生孢子梗长得像根棒棒糖。曲霉属有很多著名的物种,在食品和制药工业上作出了突出的贡献,比如米曲霉和黑曲霉等。

米曲霉孢子梗 图源:Wikipedia
被称为“酒曲”的米曲霉有着极强的消化能力。生产酱油的时候,米曲霉“吃”的是大豆和小麦; 而在酿酒的时候,它们“吃”的就是大米了。米曲霉会分泌蛋白酶和淀粉酶,把谷物中的蛋白质和淀粉分解成小分子,随后,酵母菌就能利用这些小分子发酵产生酒精。
这么纯良无害的米曲霉却是由黄曲霉驯化而来,这或许就是“一念天堂,一念地狱”——黄曲霉产生的黄曲霉素是目前已知的最强致癌物质之一。
它们无孔不入、不挑剔环境和作物,在作物收获之前还是运输过程中都可能感染。甚至吃了感染黄曲霉饲料的奶牛所产出的生鲜乳中,都会有黄曲霉素存在。它们会诱发肝癌,含量高时甚至会引起急性中毒致死。

光学显微镜下的黄曲霉(染色处理后) 图源:Vladimir Ostry
黄曲霉的“躺平”之路
1998年,通过对关键基因的深入探究,科学家们确定,米曲霉是由黄曲霉驯化得来的,但它们不产生黄曲霉素这一关键变化,让科学家们关注到了让黄曲霉“改邪归正”的关键。
目前,他们已经记录了米曲霉基因组中和黄曲霉素合成有关的二十多个基因集群中的一系列破坏性变化。尽管菌株变化的范围很大,但在不同的菌株中,黄曲霉毒素基因簇中都存在一个相同的缺失。

米曲霉菌株在25℃条件下培养7天的外观和分生孢子 图源:researchgate
这一发现表明,米曲霉来源于一个基因突变发生缺失的野生黄曲霉菌株。此后,由于合成毒素的关键基因无法起作用,其他遗传变异在黄曲霉毒素基因中自由积累,使得米曲霉在形态上表现出极大的多样性。
黄曲霉素会杀死其他存在竞争的微生物。米曲霉菌株失去了合成黄曲霉素的能力,也就让第一阶段发酵完成后,酵母和其他微生物在它们的代谢产物基础上生长繁衍成为可能——酵母不会被杀灭,而是继续发酵产生酒精和其他产物,从人类的角度来看,酱油和酒就能顺利产生。

对于曲霉来说,这也不是坏事,人类所提供的发酵环境让它有足够的食物来源,从根本上消除了竞争压力(米曲霉:我躺平啦)。

科学家们设想的微生物驯化过程:它们是如何适应相对单一的环境的。
当米曲霉放弃了合成黄曲霉素之后,它们就专注于基础代谢了。毕竟,像防御类毒素这样的次生代谢产物的合成非常消耗能量,节省下来的能量被用来消化淀粉、糖和蛋白质,并支持它们的生长繁殖。
米曲霉消化能力的强化甚至进行了不止一次。早在1989年科学家就证明了米曲霉基因组中,编码α-淀粉酶(淀粉消化酶)的基因有很多个拷贝,在食物充足的环境中,拥有的α-淀粉酶基因越多,产生的这种酶就越多,在驯化过程中,消化淀粉效率高的微生物会更多地被选择,加快发酵的速度。

日本江户时代生产酱油的示意图,右上角部分,曲霉被拌入大豆和小麦中。
图源:日本国立国会图书馆
事实上,与这些微生物发生接触、进行筛选的过程可能在人类进化的早期就开始了——我们不难想象,原始人在采集成熟的果实时,会吃到酵母轻微发酵的水果,它们口感更好、更容易消化,而另一些则可能会发酸、变苦甚至有毒,在反复试验之后,人类自然知道应该选择怎样的果子,也就选择了对应的菌株。
以曲霉属为例,约380万年前,黄曲霉和米曲霉产生了分化,在采集野生稻米的过程中,人类发现了这些不产生毒素的霉菌。
犬系菌株 VS 猫系菌株
一些霉菌会让食物腐败变质,但另一些却让食物能保存更久。鲜奶过一天可能就会变质,但硬质奶酪的保质期可能长达几个月。从新石器时代开始,人类可能就在利用曲霉菌保存食物。
对我国河南省的新石器时代遗址——贾湖遗址的出土的陶器残片进行分析,发现里面含有酒石酸,确认了里面曾经装有果汁、蜂蜜和大米发酵产生的古酒。在同属新石器时代的关桃园遗址中,也发现了微生物的痕迹。

关桃园遗址中发现的微生物痕迹,看起来和米曲霉、酵母等发酵常用的菌种很像。图源:L. LIU ET AL / PNAS 2019
有些微生物在被人类选择之后,就一直生活在人为的环境里;有些则依然能适应野外环境,只在特定季节被利用并没有被完全驯化。常年生活在酒桶里的啤酒酵母属于“犬系”菌株,而葡萄酒酵母还是自然生长在果皮上,只在果实收获的季节被用来发酵,是“猫系”菌株。
至于米曲霉,现代的米曲霉毫无疑问属于犬系,它们被高度纯化,产生了丰富多样的菌株类型,人们可以根据自己对发酵时间乃至风味的特殊需求挑选菌株。
而古人所用到的酒曲里的曲霉,是猫系菌株,由于并没有被长时间培养和纯化,酒曲中存在多种多样的微生物,以无害的米曲霉为主,里面可能还混杂着许多相近的野生菌种,这些野生菌种就有可能产生毒素——这也是自酿酒的安全更缺乏保障的重要原因。
来源:博物




- 大胆女主播视频在线观看(王秋儿大美女多次出现走光问题,动作太大胆了,还露出了特殊区域)
- 短发女主播有谁(干练短发的主持人,是《广东新闻联播》第一美女吗?)
- 美女主播自己解开胸衣(墨西哥天气预报女主播前凸后翘 英国女主播直播露胸罩)
- 女主播野外磁力(「福利」-新磁力搜索,无限期使用高级线路)
- 女主播酸奶视频(主播强迫精神残疾女孩低俗直播,最新进展)
- 女主播苏恩视频(苏恩休假直播户外,男粉丝“尾随”到三亚,这张面孔是老熟人了)
- 女主播小便视频(网红主播在酒店烧水壶撒尿,长期警示并封号)
- 美女主播小白兔(广西柳州唱功超强的网红主播—兔子牙,真名朱容君)
- 韩国女主播脱内衣视频(韩国音乐节目直播出事故歌手突然脱裤子吓坏观众)
- 女主播露屁屁视频(女主播介绍车型时多次展露裙底,画面太热血沸腾,网友直呼受不了)




